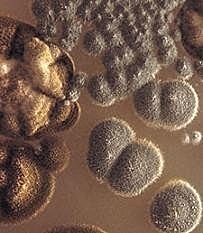
Primeras observaciones de los microorganismos
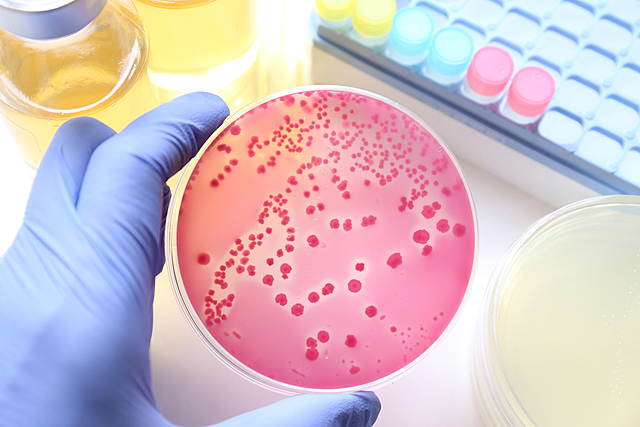
Virus

-
Observó "animalitos" (Antony Leeuwenhoek) Denominados animáculos y descubiertos después de la invención de microscopio
-
Primeros científicos observaron en primer lugar el virus de la viruela (Edward Jenner)
-
Abogó por el lavado de manos para detener la propagación de la enfermedad (Ignaz Semmelweis)
-
Refuto generación espontánea (Louis Pasteur) (generación espontanea: es una antigua teoría biológica que sostenía que ciertas formas de vida (animal y vegetal) surgen de manera espontánea a partir ya sea de materia orgánica, inorgánica o de una combinación de las mismas.)
-
Alemania apoya la teoría de la enfermedad (Louis Pasteur)
-
Ejerció la cirugía antiséptica (Joseph Lister)
-
Primera prueba de la teoría germinal de la enfermedad con anthracis descubrimiento (Robert Koch)
-
Crecimiento de bacterias en medios sólidos (Robert Koch)
-
Primera vacunación contra rabia (Louis Pasteur)
-
Descubierto virus (Dmitri Iosifovich Ivanovski)
-
Reconoció la dependencia de las células virales para la reproducción (Martinus Beijerinck)
-
Demostrado los mosquitos llevaron el agente de la fiebre amarilla (Walter Reed)
-
Descubierta la cura para la sífilis (Paul Ehrlich)
-
Descubrió la penicilina (Alexander Fleming)
-
Desarrollo un método de secuencia de ADN (W. Gilbert y F. Sanger)
-
Reacción en Cadena de la Polimerasa inventado (Kary Mullis)
-
Looking for a timeline maker?
Create timelines for projects, roadmaps, history, lessons, legal cases, and stories with Timetoast. Timetoast is a timeline maker for work, school, research, and stories.